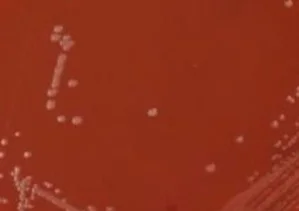
benh-lau-6

Xạ trị (radiation therapy hay radiotherapy) là phương pháp điều trị ung thư sử dụng liều lượng bức xạ để tiêu diệt tế bào ung thư và thu nhỏ khối u. Ở liều lượng cao, xạ trị tiêu diệt tế bào ung thư hoặc làm chậm sự phát triển của chúng bằng cách làm hỏng DNA. Tế bào ung thư có DNA bị hư hỏng ngoài khả năng sửa chữa sẽ ngừng phân chia hoặc chết. Khi các tế bào bị tổn thương chết đi, chúng sẽ bị cơ thể loại bỏ.
Để có thể thực hiện được một quy trình xạ trị đầy đủ cần có sự phối hợp của các nhân viên với vai trò khác nhau như bác sĩ chuyên khoa về xạ trị (radiation oncologist), kỹ thuật viên xạ trị (radiation therapists), chuyên gia vật lý y tế (radiation oncology medical physicists – ROMPs), và điều dưỡng viên (radiation oncology nurses).
Radiation therapists là những người mà bệnh nhân gặp hàng ngày, họ tiến hành xạ trị. Họ làm việc chặt chẽ với bác sĩ để tính toán việc lập kế hoạch xạ trị, và họ vận hành công nghệ cùng thiết bị hình ảnh tiên tiến để đảm bảo việc điều trị được thực hiện một cách chính xác và an toàn. Trong suốt quá trình điều trị, bệnh nhân trở nên quen thuộc với đội ngũ kỹ thuật viên xạ trị của họ. Kỹ thuật viên xạ trị thường có thể trả lời bất kỳ câu hỏi hoặc thắc mắc nào của bệnh nhân về bệnh ung thư hoặc cách điều trị của họ, và có thể hướng dẫn họ đến chuyên gia chăm sóc sức khỏe thích hợp nếu được yêu cầu.
ROMPs là các chuyên gia về vật lý bức xạ. Họ đánh giá và giám sát sự an toàn của bệnh nhân và nhân viên tham gia vào quá trình xạ trị. Họ làm việc với các thành viên khác của nhóm như các nhân viên về công nghệ thông tin và kỹ thuật để đảm bảo tất cả các thiết bị xạ trị và máy tính hoạt động hoàn hảo nhằm đáp ứng các tiêu chuẩn quốc tế và quốc gia. ROMPs giám sát an toàn, hỗ trợ bác sĩ và kỹ thuật viên xạ trị trong việc lập kế hoạch xạ trị, đồng thời chịu trách nhiệm đảm bảo rằng thiết bị được thiết lập và hiệu chỉnh chính xác khi nó được lắp đặt lần đầu. Họ cũng tạo ra, thực hiện và giám sát các công nghệ điều trị bức xạ ung thư tiên tiến.
 |
 |
Tại trường Đại học Y khoa Tokyo Việt Nam (THUV), các bài học về xạ trị sẽ được các chuyên gia, nhà vật lý hàng đầu Nhật Bản về xạ trị dạy trực tiếp. Nội dung bài giảng bao trùm sâu rộng về các công nghệ hiện đại trong xạ trị, các mô hình xạ trị như EBCT hay Brachytherapy, cũng như các kỹ thuật áp dụng cho từng loại ung thư khác nhau được cập nhật liên tục tại Nhật Bản và trên thế giới như 3D-CRT, IMRT, VMRT, VMRT, IGRT, IORT, SBRT hay SABR. Cũng tại đây, sinh viên sẽ bước đầu làm quen với các nguyên lý kỹ thuật trong xạ trị và việc tham gia vào lập kế hoạch xạ trị. Sau khi kết thúc chương trình Cử nhân kỹ thuật hình ảnh Y học, sinh viên ra trường có thể trở thành một kỹ thuật viên xạ trị hoặc tiếp tục học lên cao hơn (thạc sĩ hay tiến sĩ) để trở thành một chuyên gia vật lý xạ trị.
Hãy đến với THUV để thực hiện ước mơ của bạn!
TS. Trần Văn Biên – Ngành Kỹ thuật hình ảnh y học
🇯🇵 🇯🇵 🇹 🇺 🇾 🇪 🇳 🇸 🇮 🇳 🇭2️⃣⭕2️⃣2️⃣🇻🇳 🇻🇳🇯🇵 🇯🇵 🇹 🇺 🇾 🇪 🇳 🇸 🇮 🇳 🇭2️⃣⭕2️⃣2️⃣🇻🇳 🇻🇳
https://tokyo-human.edu.vntuyen-sinh/thuv2022/